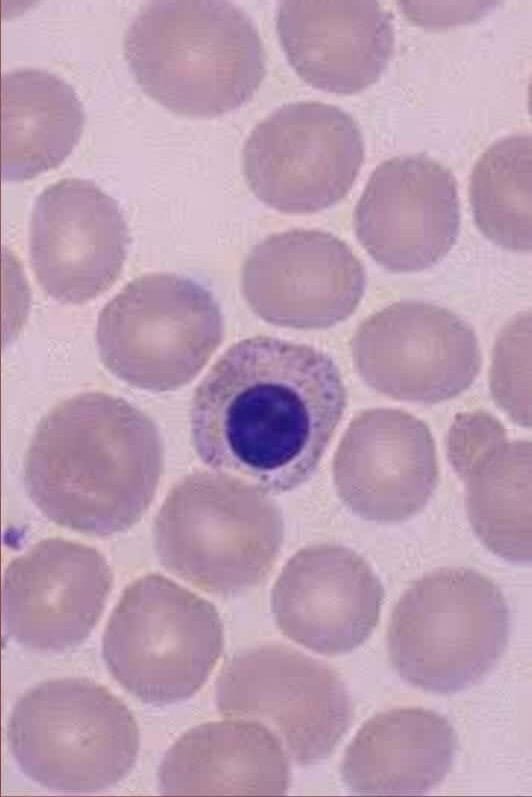

Método “Microscopia Sem Medo™” – Um sistema de ensino que vai além da teoria, trazendo casos reais e correção técnica para garantir aprendizado 100% aplicável.

Sim! O método combina teoria online com prática guiada. Além disso, a imersão presencial garante que você aplique tudo o que aprendeu.
Não! A mentoria foi desenvolvida para ensinar do zero até o nível avançado.
As datas são definidas pela mentora, e os alunos são informados com antecedência.
Não, você terá acesso ao conteúdo durante um ano.
Sim! Profissionais especializados em microscopia têm mais oportunidades e melhores salários.
